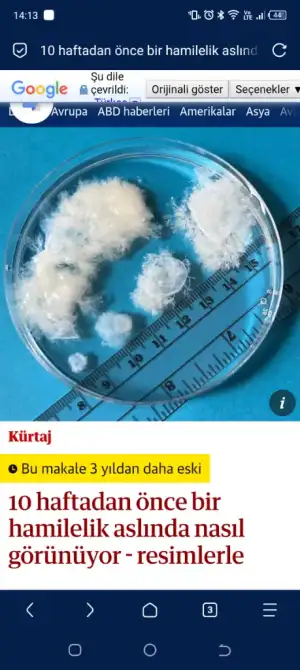
1000016262.webp

Adinizla musemmasiniz, sizi ilgilendirmiyor, iyi gunler.Doğru karar. 25 yaşından 1 gün büyükseniz çok şaşırır ve sizin adınıza çok üzülürüm. Yasal kürtaj için de gerçek hayatta orda burda katillik falan yazmayın derim avukat olarak komik duruyor. Icinizde kalsin.
Web uygulamasını kur
How to install the app on iOS
Aşağıdaki videoyu izleyerek sitemizi ana ekranınıza web uygulaması olarak nasıl kuracağınızı öğrenebilirsiniz.
Not: Bu özellik bazı tarayıcılarda mevcut olmayabilir.
-
Merhaba, Kadınlar Kulübü'ne ÜCRETSİZ üye olarak yorumlar ile katkıda bulunabilir veya aklınıza takılan soruları sorabilirsiniz.
Son kullanma tarihi geçmiş, bayatlamış bir tarayıcı kullanıyorsanız. Mercedes kullanmak yerine tosbaya binmek gibi... Websiteleri düzgün görüntüleyemiyorsanız eh, bi zahmet tarayıcınızı güncelleyiniz.
Modern Web standartlarını karşılayan bir tarayıcı alternatifine göz atın.
Modern Web standartlarını karşılayan bir tarayıcı alternatifine göz atın.
Kürtaj Kararsızlığı
- Konu Sahibi bartilan
- Başlangıç Tarihi
- Durum
- Mesaj gönderimine kapalı.
Ayrıntılı Düzenleme
Kimler kimler yazdı?- 18 Ekim 2025
- 151
- 367
- 18
- 33
Bizim ülkedeki kürtaj karşıtlığı ABD’yle yarışır herhalde. Bence istemiyorsanız iki çocukla bile zorlanırken 3. İle ekstra zorlanacaksınız maddi ve manevi doğurmamalısınız. Bu bizzat çocuğun iyiliği için.
Ben 2013 senesinde köyde yaşayan bir akrabamızın evine gitmiştim. Tahminen 2 yaşlarında falan bir engelli bir kızı vardı, zihinsel engeli vardı. Çok da tatlı bir kızdı, yüzde yüz değildir muhtemelen insanın yanına gelip sevilmek istiyordu. Annesi kızı alıp odaya kapatıyordu. O kadar üzülmüştüm ki, ne zararı var sana yani. Salyası akıyordu diye yaptı. Bu yıl annem gitmiş, o kıza nasıl davranıyorlar dedim, eline bir kuru ekmek verip gene odaya falan kapatıyorlar dedi. Bu insanlar dindar bir de, doktor bunlara çocuk zihinsel engelli aldır demişse ya da deseydi aldırmayız, Günah derlerdi. Allahtan korkup aldırmazlardı ya da aldırmadılar. Ama çocuğa davranışları hiç allahtan korkar bir hal taşımıyor. Hani şikayet et kurum alsın derseniz; kurumda zeka engelli bir kzıın başına neler geleceğini tahmin edemiyorum. Muhtemelen engelli aylığı, evde bakım aylığı vs de alıyorlar.
Henüz pıhrı olan bir varlığın yaşamına son vermek küçüktür onu maddi ve manevi eksik koşullarda büyütmek. Bizimkilerin aldırma o bu seçeneği yokmuş kimse korun da demiyormış, gelişine doğurmuşlar. Yetişkin insanların kürtaj seçeneği var gayet.
Ben 2013 senesinde köyde yaşayan bir akrabamızın evine gitmiştim. Tahminen 2 yaşlarında falan bir engelli bir kızı vardı, zihinsel engeli vardı. Çok da tatlı bir kızdı, yüzde yüz değildir muhtemelen insanın yanına gelip sevilmek istiyordu. Annesi kızı alıp odaya kapatıyordu. O kadar üzülmüştüm ki, ne zararı var sana yani. Salyası akıyordu diye yaptı. Bu yıl annem gitmiş, o kıza nasıl davranıyorlar dedim, eline bir kuru ekmek verip gene odaya falan kapatıyorlar dedi. Bu insanlar dindar bir de, doktor bunlara çocuk zihinsel engelli aldır demişse ya da deseydi aldırmayız, Günah derlerdi. Allahtan korkup aldırmazlardı ya da aldırmadılar. Ama çocuğa davranışları hiç allahtan korkar bir hal taşımıyor. Hani şikayet et kurum alsın derseniz; kurumda zeka engelli bir kzıın başına neler geleceğini tahmin edemiyorum. Muhtemelen engelli aylığı, evde bakım aylığı vs de alıyorlar.
Henüz pıhrı olan bir varlığın yaşamına son vermek küçüktür onu maddi ve manevi eksik koşullarda büyütmek. Bizimkilerin aldırma o bu seçeneği yokmuş kimse korun da demiyormış, gelişine doğurmuşlar. Yetişkin insanların kürtaj seçeneği var gayet.
- 30 Ekim 2023
- 795
- 1.697
- 43
Erken iş hayatı erken yaşlanmak demek. Kürtaja olumsuz bakan mahalle baskısının sonuçları cidden göz ardı edilecek gibi değil. Diğer araştırmalarsa şunlarBuna bir örnek benim kocam mesela.
abisiyle de kardeşiyle de 2 yaş var arasında/ abi okuyamamış erkenden çırak olmuş işe girmiş. Küçük olan lisedeyken başka şehirde kocamı okutamayacakları için dershaneye bile gitmeden kendi çabasıyla üç büyük şehirde iyi bir bölüm okumuş. Ama kardeşi olmasa başka uzak bir şehirde diş hekimliği okuyabiliyormuş. Keza okul bitince tüm arkadaşları o dönem okul puanı ve ales puanı en yüksek oyken başvuramamış kardeşi hala okuduğu için iş hayatına atılmış. 20 yaşından beri çalışıyor. Belki ailesi iki çocukta kalsa şu an bambaşka bir hayatı vardı
Eklentiler
Siz maşallah her bir şeyin icindesiniz ama. Daha bebek doğmamış bile masraf profesörü olmuşsunuz hepimizden cok biliyormussunuz yazdığınıza göre.Adinizla musemmasiniz, sizi ilgilendirmiyor, iyi gunler.
Birisini öldürmemiş ölümüne sebep olmamış birine cinayet işledin katilsin diyemezsiniz ama. Kendi görüşünüze inancınıza göre suçlu diyemezsiniz. Kimse size mahalle baskısı yapma hakkını da vermiyor ama cinayet diyip bu baskıyı yapıyorsunuz. Annenin fiziksel ruhsal sağlığının önemi yok, doğacak olanın yiyeceği giyeceği var mı onu sormak da yok. Yeter ki sizin inancınıza göre davranılsın gerisinden size ne. Bakımına masrafına siz ortak olmayacaksınız, kadın çökerse çöksün orası da sizi enterese etmiyor değil mi? Cahil sorumsuz bencil vs. diyin ama cinayet demeyin.Bir şeyin suç olmaması doğru olduğunu göstermez ki bu arada. Mesela 80 yaşında Bi adam yasalara gore 18 yaşında bi kızla evlenebilir. Ama benim buna yanlış deme hakkım var. Bence bildiğin sapıklık çünkü.
Musaade etmiyorsunuz ki sizlerle muhatap olmayayım. Yineliyorum, son kez olsun. İsinize gelmedigi icin beni baltalamaya calismayin. Sizin fikirleriniz benim umurumda degil benimki de sizinkilerin olmasin, konu sahibi benimle tartisiyor olsaydi memnuniyetle cevaplardim ancak sizler ne alaka… ben sizinle farkli inanc ve felsefi goruse sahibim.Siz maşallah her bir şeyin icindesiniz ama. Daha bebek doğmamış bile masraf profesörü olmuşsunuz hepimizden cok biliyormussunuz yazdığınıza göre.
Benim vicdanim ve inancim musaade etmiyor. Eger ki hanimefendi korunurken gebe kalsa idi yorum yapmaz geçerdim, ancak korunmadan iliskiye girip zaten halihazirda gebeliği tetikleyen bir surecteyken kolayca gebe kalip olmadi aldirayim mi kararsizim diyorsa gayet tabii fikir beyan ederim ve biliyor musunuz, sizi hic ilgilendirmez.
Ayrica ben yillardir yasayan biri olarak her seyin profesoru olurum, size ne? Yasadigim icin ve gordugum icin birtakim seylerin ileri donemde cozulme ihtimali varsa cocugu aldirmanin anlami olmadigini söylüyorum ancak sonrasinda cozulmeyecekse o vicdanina kalir, beni de ilgilendirmez. Kaldi ki benim anneligim benim anneligimdir, bu da sizi ilgilendirmez. Masrafi bakimindan onu ifade ettim, ilerisi icin de yasantimdan bildigimi ifade ettim. Ancak yineliyorum madem cozulmeyecek bir sorun vardi cocuk yapmadan dusunseydi. Surada kendinizi de paralasaniz vazgecmeyecegim, gebelikte ve bebekte sorun yoksa ( ya da kadinin rizasi disinda suc teskil eden eylemlerin neticesi, verdigi elem izdirap ayri kalmak suretiyle) kurtaj yanlistir. Size ne? Hanimefendi size ne :) her hak hukuki degildir, yani sira benim meslegimle dünya görüşüm catisiyorsa dunya gorusumu secerim.
Burada kisisel fikir beyan ediyoruz ama Bu kadin bana muvekkil olarak gelse idi başka, hukuki kismi soyler gecerdim, benim fikrimden ona ne? Burada profosyonel is yapmiyoruz kisisel fikir beyan ediyoruz, bana artik kendi kafa yapinizi kabul ettirmeye calismayin, etmeyecegim icin diyorum ki daha fazla cevap vermeyecegim size, SİZE NE! :))))
- 11 Nisan 2019
- 1.436
- 4.053
- 133
Sizin bu söylediğiniz çocuğunu bu haftalarda kaybedenler için çok kırıcı haberiniz olsun. Farkında olmayıp ilaç kullananlar, alkol alanlar, kronik rahatsızlığını bilmeden çocuğunu kaybeden veya aldırmak zorunda kalanlar…Ya şimdi oturup uzun uzun o 7haftalik kan pıhtısınin içeriğini anlatsam ne fayda. Ben fikrimi söyledim kardeşim, isteyen öldürmeye devam etsin
Ben tüplerimde sıkıntı olduğunu bilmediğimden ilk çocuğumu bu haftalarda kaybettim mesela. Biraz dikkatli mi olsanız?
Bana kalırsa suça meyilli olan ya da çeşitli ruhsal bozukluğu olan insanların çocuk yapması da günah.fiziksel durumları zaten sen anlatmışsın.benim teyzemin akıl hastası denilebilecek bir kocası var.çocukları babadan etkilenmeden yetiştireceğim diye canı çıktı.şimdi birinde şizofren başlangıcı varmış 20 yaşında, biri de illegal işlerle uğraşıyordu hapiste şimdi.bunlar birilerini öldürse anası niye boyle bir adamdan çocuk yaptı diyebilir miyiz? Ya da demeli miyiz? ne yaparsan yap genlerden geliyor demek ki.daha birçok örneği var.tam olarak kürtajı da savunuyor gibi olmuyorum aslında kafam karışık demek daha doğru.biriyle ilişki yaşamaya karar vermek de bizim kararımız mesela.belki hiç evlenmeseydik kazayla hamile de kalmayacaktik.sevişmeyeni dövmüyorlar yani.ilişki yaşamak bizim tercihimiz, seks yapmak bizim tercihimiz eee kaç çocuğu ne zaman doğuracağımız da mecburen bizim tercihimiz olmalı bana kalırsa.eee belki 20 yaşında evlensen 4 tane çocuğun olacaktı.30 yaşında evlendin 1 tane oldu ya da hiç olmadı.bir de pek kaltılmıyor arkadaşlar ama korunmakla kürtaj olmak da çok farkli gelmiyor bana.eee hiç korunmasan belki 10 tane olacaktı.onların da mı yaşama hakkina girmiş oluyorsun şimdi? Zaten bir kısım doğum kontrol yöntemleri döllenmeden sonra rahme tutunmayı engelliyor.demek istediğim bu işlere girersen pek çıkamıyorsun.karışık işler.Bizim ülkedeki kürtaj karşıtlığı ABD’yle yarışır herhalde. Bence istemiyorsanız iki çocukla bile zorlanırken 3. İle ekstra zorlanacaksınız maddi ve manevi doğurmamalısınız. Bu bizzat çocuğun iyiliği için.
Ben 2013 senesinde köyde yaşayan bir akrabamızın evine gitmiştim. Tahminen 2 yaşlarında falan bir engelli bir kızı vardı, zihinsel engeli vardı. Çok da tatlı bir kızdı, yüzde yüz değildir muhtemelen insanın yanına gelip sevilmek istiyordu. Annesi kızı alıp odaya kapatıyordu. O kadar üzülmüştüm ki, ne zararı var sana yani. Salyası akıyordu diye yaptı. Bu yıl annem gitmiş, o kıza nasıl davranıyorlar dedim, eline bir kuru ekmek verip gene odaya falan kapatıyorlar dedi. Bu insanlar dindar bir de, doktor bunlara çocuk zihinsel engelli aldır demişse ya da deseydi aldırmayız, Günah derlerdi. Allahtan korkup aldırmazlardı ya da aldırmadılar. Ama çocuğa davranışları hiç allahtan korkar bir hal taşımıyor. Hani şikayet et kurum alsın derseniz; kurumda zeka engelli bir kzıın başına neler geleceğini tahmin edemiyorum. Muhtemelen engelli aylığı, evde bakım aylığı vs de alıyorlar.
Henüz pıhrı olan bir varlığın yaşamına son vermek küçüktür onu maddi ve manevi eksik koşullarda büyütmek. Bizimkilerin aldırma o bu seçeneği yokmuş kimse korun da demiyormış, gelişine doğurmuşlar. Yetişkin insanların kürtaj seçeneği var gayet.
Son düzenleme:
- 16 Haziran 2011
- 17.044
- 77.050
- 798
İlerleyen zamanlarda eşinizle 1 çocuk sahibi daha olma vb gibi bir düşünceniz var mı ? Bakabilecek imkanınız ve isteğiniz varsa, bebeğinizden vazgeçmeyin.Merhabalar,
15 aylık ikizlerim var. Eşimle korunmadan ilişki yaşadık ve istemeden gebe kaldım. Şuan 7 haftalık be sağlıklık. Etrafımızda bize destekçi kimse bulunmuyor. ikizlerime tek başıma kendim bakıyorum. Maddi olarak çok sıkıntılıyız. Eşimde bende çocuğu dünyaya getirme konusunda emin değiliz. Maddi boyutudan ziyade evde bir anda 3 bebek ve gündüz tek başıma ilgileneceğim. Hamilelik sırasında ikizlerime nasıl ilgi göstereceğim gibi konular kafamda duruyor.
Maddi durumumuz daha iyi olsa yardımcı alır bu çocuğu da dünyaya getirirdim. Kafam allak bullak...
- 1 Mart 2014
- 859
- 1.890
- 313
Ben 7den de once kaybettim ilk hamileligimde. Aylarca yasini tuttum. O yüzden ona pıhtı denmesi de benim kalbimi kırıyor. Kaybınıza üzüldüm.Sizin bu söylediğiniz çocuğunu bu haftalarda kaybedenler için çok kırıcı haberiniz olsun. Farkında olmayıp ilaç kullananlar, alkol alanlar, kronik rahatsızlığını bilmeden çocuğunu kaybeden veya aldırmak zorunda kalanlar…
Ben tüplerimde sıkıntı olduğunu bilmediğimden ilk çocuğumu bu haftalarda kaybettim mesela. Biraz dikkatli mi olsanız?
- 18 Ekim 2025
- 151
- 367
- 18
- 33
Bana kalırsa suça meyilli olan ya da çeşitli ruhsal bozukluğu olan insanların çocuk yapması da günah.fiziksel durumları zaten sen anlatmışsın.benim teyzemin akıl hastası denilebilecek bir kocası var.çocukları babadan etkilenmeden yetiştireceğim diye canı çıktı.şimdi birinde şizofren başlangıcı varmış 20 yaşında, biri de illegal işlerle uğraşıyordu hapiste şimdi.bunlar birilerini öldürse anası niye boyle bir adamdan çocuk yaptı diyebilir miyiz? Ya da demeli miyiz? ne yaparsan yap genlerden geliyor demek ki.daha birçok örneği var.tam olarak kürtajı da savunuyor gibi olmuyorum aslında kafam karışık demek daha doğru.biriyle ilişki yaşamaya karar vermek de bizim kararımız mesela.belki hiç evlenmeseydik kazayla hamile de kalmayacaktik.sevişmeyeni dövmüyorlar yani.ilişki yaşamak bizim tercihimiz, seks yapmak bizim tercihimiz eee kaç çocuğu ne zaman doğuracağımız da mecburen bizim tercihimiz olmalı bana kalırsa.eee belki 20 yaşında evlensen 4 tane çocuğun olacaktı.30 yaşında evlendin 1 tane oldu ya da hiç olmadı.bir de pek kaltılmıyor arkadaşlar ama korunmakla kürtaj olmak da çok farkli gelmiyor bana.eee hiç korunmasan belki 10 tane olacaktı.onların da mı yaşama hakkina girmiş oluyorsun şimdi? Zaten bir kısım doğum kontrol yöntemleri döllenmeden sonra rahme tutunmayı engelliyor.demek istediğim bu işlere girersen pek çıkamıyorsun.karışık işler.
Dini açıdan bakıldığında zaten korunmak da günah esasen. O konulara girmek istemiyorum, ama insanımız çocuk rızkıyla gelir, yok cana kıyıyırsın diye diye nice insanı helak ediyor. Yetiştirme yurtlarındaki çocukların hali zaten perişan. Kürtaj olsalar o çocuklar eminim daha mutlu olurlardı. Yani tercih hakkı verilse doğmamayu tercih ederdi.
Gidiyorum yetiştime yurdundaki çocuk suç işlemiş, soruyorum anne baba hayatta, yeni çocuklar da yapılmış, ama bakmıyorlar atıyorlar yurda. Bakma niyetin yoksa doğurma yani.
- 30 Ekim 2023
- 795
- 1.697
- 43
5.haftadan 9. Haftaya geçiş. Yani 10. Haftadan önceki görünüş.

 www.theguardian.com
www.theguardian.com

What a pregnancy actually looks like before 10 weeks – in pictures
In 13 US states, abortion is banned even in the earliest stages of pregnancy. But we rarely see what such tissue really looks like
Eklentiler
- 7 Kasım 2023
- 2.673
- 4.722
- 63
- 41
Maddi durumum yok çocuk bakmaya diyor, 500 TL devede kulak bile değil500 lirayı geçti kız.
- 8 Mart 2019
- 7.752
- 38.772
- 548
- 40
Oğlum anaokulundan beri kolejde ve 3 çocuklu tek bir aileye denk geldim. Onlarda gerçekten maddi olarak hem iyilerdi hem de diğer çocukları büyüktü, sonuncuyu muhtemelen sonradan istemişlerdi.Oğlum özel okulda mesela (muhtemelen en fakirlerden biri biziz)ve bizim sınıfta çoğunluk tek çocuk. 24 kişilik sınıfta 8 tanesi iki kardeş kalanlar tek çocuk.
Bu bile aslında bunun kanıtı
Onun dışında dediğin gibi çoğunluk tek çocuk ya da Max 2. Maddi durumu iyi olan çoğu aile fazla çocuk yapmıyor, elindekine daha iyi imkanlar sunmanın peşinde herkes.
- 7 Kasım 2023
- 2.673
- 4.722
- 63
- 41
Mazeret mi? Bizim bebe de tüp bebek, normal olması imkansıza yakın ve korunuyoruz.Yıllarca cocuk sahibi olamadık denedik olmadı. Sonra tüp bebek oldu. Tüp bebek sonrası da olmayacağını düşünerek korunmadık. Aslında eşim korunuyordu ama sadece o gün korunmadık.
- 14 Eylül 2014
- 21.847
- En iyi cevaplar
- 1
- 106.554
- 798
Benim oğlumun okulunda da genelde karı koca akademisyen, doktor, diş hekimi, şirket sahibi gibi cidden ortalama üstü insanlar var. Biz üç beş kişi ortalama gelirliyiz dediğin gibi. Hepsinde tek çocuk. Üşenmedim son sınıf fotoğrafından saydım 8 tane iki kardeşli var. 3 çocuklu hiç yok. Daha biraz önce pizza etkinliğine bütçe ayıramayan velilerin olduğu okulda herkesin en az 2 çocuklu olduğunu yazdılar. Çok ilginç geliyor bu bana. Özel okullarda durumu iyi olanların bir iki çocuğu varken diğerleri neden durmadan çocuk yapıyor mesela?Oğlum anaokulundan beri kolejde ve 3 çocuklu tek bir aileye denk geldim. Onlarda gerçekten maddi olarak hem iyilerdi hem de diğer çocukları büyüktü, sonuncuyu muhtemelen sonradan istemişlerdi.
Onun dışında dediğin gibi çoğunluk tek çocuk ya da Max 2. Maddi durumu iyi olan çoğu aile fazla çocuk yapmıyor, elindekine daha iyi imkanlar sunmanın peşinde herkes.
- 18 Ekim 2025
- 151
- 367
- 18
- 33
Mesela benim annem de namazında niyazda bir kadın babam da aynı şekilde, 2 çocuk kaybetmiş - biri 2 biri 9 yaşında- son bebeğini de babamın zoruyla aldırmış. Bir kadının 10 kere hamile kalması bile korkunç bir durum. Hala der ki keşke aldırmasaydım, babanız yüzünden o da sizinle büyürdü ne olacak. Gel de bize sor ne olacak, biz ne şartlarda büyüdük, nasıl gözümüz elalemde kaldı. Eşim bazen dalga geçiyor lütfen fakirlik anılarını anlatma diye. Üniversite okuyan tek ben olabildim o da üniversite hazırlık bedavaya geldi sınavlar sayesinde, üniversitede burs aldım kredi aldım falan. Lise zamanım tamamen travma dolu, çünkü maddi durumu orta halli orta üst insanların içinde büyüdüm, ayakkabım kıyaferim hepsi alay konusu oldu, onlar gibi olamadım hiçbir zaman, özgüvenim düşüktü.
O yüzden saçma sapan şartların içine çocuk doğuran, çocuğunu yurda atan herkes de hapse girse, ya da doğurganlıkları devlet kanalıyla engellense hayır demem. Hala o gariban kızın hüznü içimden çıkmıyor benim.
O yüzden saçma sapan şartların içine çocuk doğuran, çocuğunu yurda atan herkes de hapse girse, ya da doğurganlıkları devlet kanalıyla engellense hayır demem. Hala o gariban kızın hüznü içimden çıkmıyor benim.
- 14 Ekim 2021
- 473
- 1.041
- 63
- 45
- 8 Mart 2019
- 7.752
- 38.772
- 548
- 40
Benimde dini inancıma göre de kürtaj bir seçenek değil ama Allah kullanalım diye akıl vermiş değil mi?Musaade etmiyorsunuz ki sizlerle muhatap olmayayım. Yineliyorum, son kez olsun. İsinize gelmedigi icin beni baltalamaya calismayin. Sizin fikirleriniz benim umurumda degil benimki de sizinkilerin olmasin, konu sahibi benimle tartisiyor olsaydi memnuniyetle cevaplardim ancak sizler ne alaka… ben sizinle farkli inanc ve felsefi goruse sahibim.
Benim vicdanim ve inancim musaade etmiyor. Eger ki hanimefendi korunurken gebe kalsa idi yorum yapmaz geçerdim, ancak korunmadan iliskiye girip zaten halihazirda gebeliği tetikleyen bir surecteyken kolayca gebe kalip olmadi aldirayim mi kararsizim diyorsa gayet tabii fikir beyan ederim ve biliyor musunuz, sizi hic ilgilendirmez.
Ayrica ben yillardir yasayan biri olarak her seyin profesoru olurum, size ne? Yasadigim icin ve gordugum icin birtakim seylerin ileri donemde cozulme ihtimali varsa cocugu aldirmanin anlami olmadigini söylüyorum ancak sonrasinda cozulmeyecekse o vicdanina kalir, beni de ilgilendirmez. Kaldi ki benim anneligim benim anneligimdir, bu da sizi ilgilendirmez. Masrafi bakimindan onu ifade ettim, ilerisi icin de yasantimdan bildigimi ifade ettim. Ancak yineliyorum madem cozulmeyecek bir sorun vardi cocuk yapmadan dusunseydi. Surada kendinizi de paralasaniz vazgecmeyecegim, gebelikte ve bebekte sorun yoksa ( ya da kadinin rizasi disinda suc teskil eden eylemlerin neticesi, verdigi elem izdirap ayri kalmak suretiyle) kurtaj yanlistir. Size ne? Hanimefendi size ne :) her hak hukuki degildir, yani sira benim meslegimle dünya görüşüm catisiyorsa dunya gorusumu secerim.
Burada kisisel fikir beyan ediyoruz ama Bu kadin bana muvekkil olarak gelse idi başka, hukuki kismi soyler gecerdim, benim fikrimden ona ne? Burada profosyonel is yapmiyoruz kisisel fikir beyan ediyoruz, bana artik kendi kafa yapinizi kabul ettirmeye calismayin, etmeyecegim icin diyorum ki daha fazla cevap vermeyecegim size, SİZE NE! :))))
Tanıştığım maddi durumu kötü bir hanımefendi vardı, çevresi başka çocuk dogur diyormuş. ' buna bile istediğim imkanları sunamiyorum, asla dogurmam' demişti. Baksan eğitimsiz bir kadın ama akıllı. Keşke o kadindaki bilinç çoğu insanda olsa..
- 14 Eylül 2014
- 21.847
- En iyi cevaplar
- 1
- 106.554
- 798
Rızıktan kastınız da kuru ekmek, makarna, bulgur muhtemelen.Ben doğurun derim, Allah size ne güzel bir sağlıklı evlat vermiş, onca yıl hasretlikten sonra olmuş kendiliğinden. Allah rızka kefil , lükse değil !
Bu yaz kilosu 100den aşağı armut yiyemedik zira. Dört tane armuda 150 tl verdiğimi bilirim ben.
- Durum
- Mesaj gönderimine kapalı.